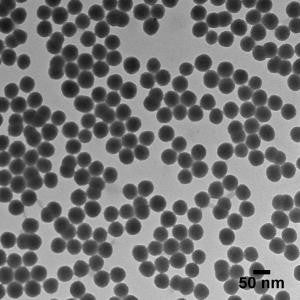
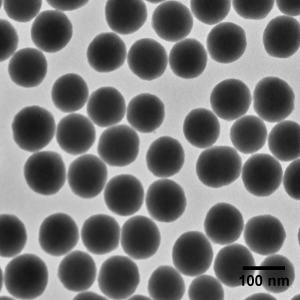
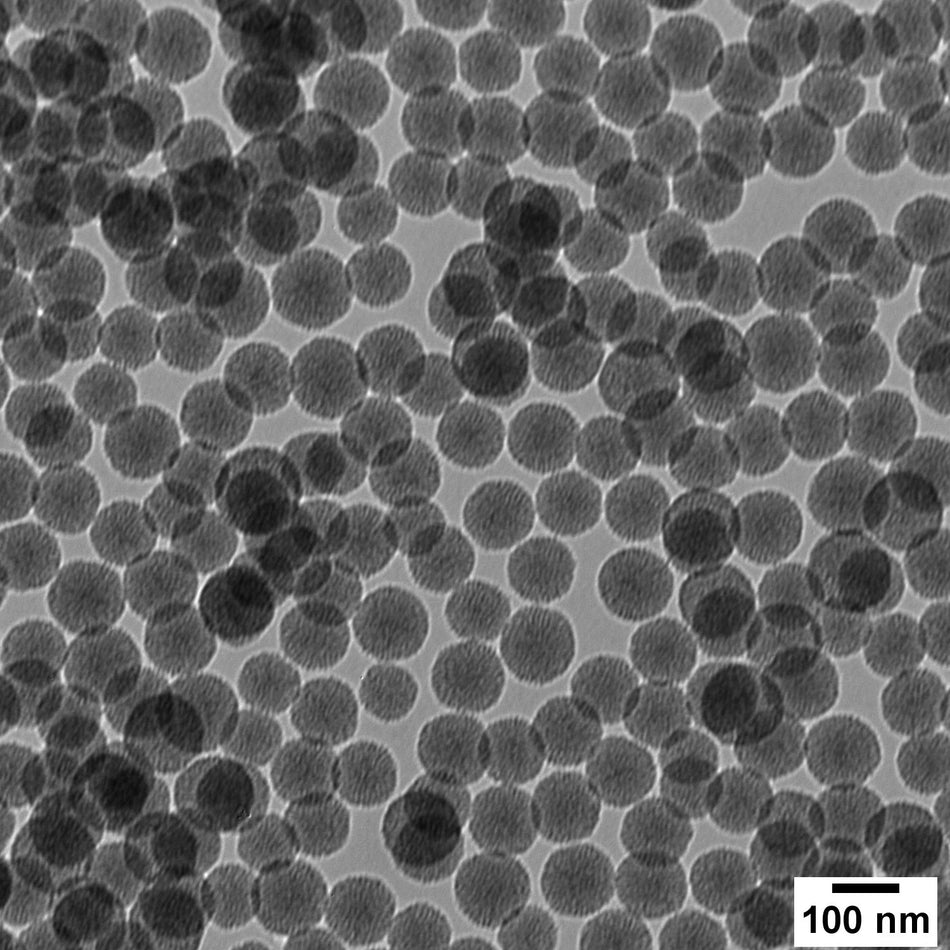

13 Products
Silica nanoparticles from nanoComposix are trusted across targeted drug delivery, UV-scattering, and particle size references for their biocompatible properties, unique optical properties, and customizable surface chemistry. Whether you're optimizing nanomedicine formulations or tuning thin film refractive index and scatter, consistent particle quality is essential to achieving reliable results.
Don’t see what you need or want technical help? Contact Us
13 Products